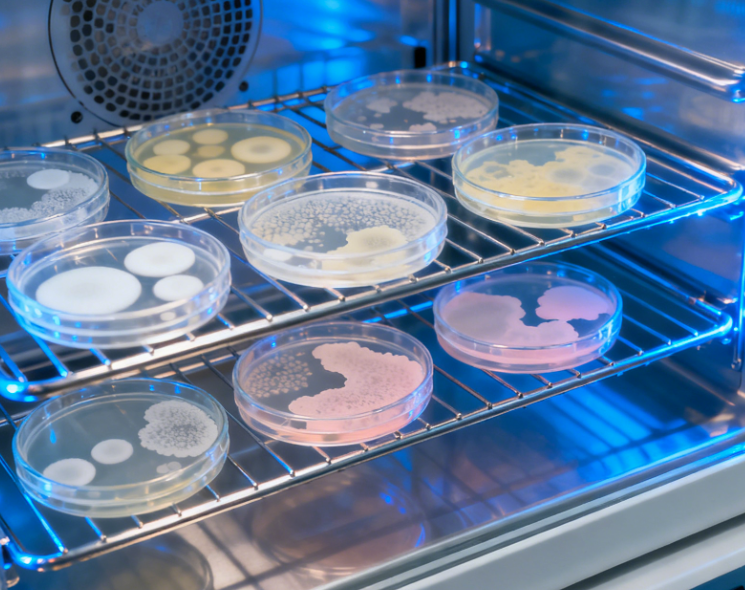
picture

Leading Laboratory Incubator Technology for Scientific Research!
Welcome to Aucma Global Medical - your trusted partner for advanced laboratory incubator technology! We specialize in comprehensive incubation solutions including constant temperature and humidity incubators, electric constant temperature incubators, biochemical incubators, mold incubators, and light incubators, all featuring microcomputer intelligent control systems with PID control programs.

Introduce of Incubator
Our advanced incubator series provides precise temperature and environmental control to meet a wide range of laboratory and industrial cultivation needs. Based on temperature range and functional requirements, the lineup includes constant temperature and humidity incubators, electric constant temperature incubators, biochemical incubators, mold incubators, light incubators, and more. Users can flexibly configure different functional modules to suit specific applications. Featuring a microcomputer intelligent control system with PID regulation, the incubators ensure stable, uniform temperature performance. The double-layer sealed door improves tightness, while the inner glass door enables observation without affecting internal conditions. An independent digital temperature limiter adds extra safety for long-term operation.
Product Advantages - State-of-the-Art Incubator Technology
Our goal is to become a global leader in laboratory equipment innovation, providing comprehensive incubation solutions for scientific research and industrial applications worldwide.
Precise and Stable Environmental Control
Our incubators are engineered to deliver highly accurate temperature and atmospheric regulation through advanced microcomputer control and PID technology. With optional IR or TCD CO₂ sensors, uniform airflow, and an energy-efficient variable-frequency cooling system, the unit maintains consistent conditions essential for reliable microbial and cell culture results.
Enhanced Safety and Contamination Prevention
Multiple protection features—such as over-temperature alarms, self-diagnosis, dual control systems, and automatic recovery after power failure—ensure safe and uninterrupted operation. A HEPA filtration system with 99.998% efficiency, UV sterilization, and optional 90°C moist-heat sterilization effectively eliminate bacteria, molds, and mycoplasma.
User-Friendly Design and Convenient Operation
The exterior is built from durable cold-rolled steel, while the interior chamber uses mirror-finished stainless steel with adjustable shelves for easy configuration. A large vacuum-insulated glass door and built-in lighting offer clear visibility without disturbing the internal environment. Touch-control buttons, intuitive menus, and a digital LCD display simplify operation, while features like a built-in 220V socket and noise-reducing imported compressor further enhance comfort and usability.
Application of Incubator
Microbial Cultivation
Photosensitive Organisms
Fungal Studies
Special Service
Fully Customized Product Solutions
Aucma offers comprehensive customization based on your specific needs, including materials, colors, the number of shelves or drawers, plug types, control panels, software interfaces, packaging, and branding (LOGO). Simply share your requirements, and we will design a tailored solution that fits your application perfectly.
Wide Range of Supported Products
Our customization services apply to multiple product categories, such as ultra-low temperature freezers, vaccine refrigerators, blood bank refrigerators, and various laboratory equipment. This ensures you can achieve consistent standards across your entire cold storage and laboratory ecosystem.
Professional After-Sales Support & Warranty Coverage
Aucma provides reliable warranty service from the date of sale: 1-year free warranty for the complete machine 3-year free warranty for major components (compressor, evaporator, condenser, filter, thermostat, control board, fan motor, etc.) Repairs involving user-caused damage or conditions outside warranty guidelines are available with paid service options.
Streamlined Customization Process
Our service workflow is designed to be efficient and customer-friendly. From requirement consultation to design, production, and delivery, each step is guided by experienced professionals to ensure accuracy, timely response, and high-quality results aligned with customer expectations.
Company Advantage
Choose Aucma as your trusted partner and elevate your cold-chain and medical storage solutions with proven quality, innovation, and global reliability.
Global High-Quality Supplier with Strong Reputation
Aucma is a trusted WHO global procurement supplier, serving customers in over 70 countries and regions. Established in 1987 and listed on the Shanghai Stock Exchange in 2000, the company has grown into one of the world’s most reliable refrigeration equipment manufacturers with a full commercial cold-chain product lineup.
Complete One-Stop Medical & Cold-Chain Solutions
Aucma provides comprehensive solutions for the safe storage and bio-safety of vaccines, blood, samples, pharmaceuticals, and laboratory materials. Its wide product portfolio covers ultra-low temperature freezers, vaccine refrigerators, blood bank refrigerators, lab equipment, commercial coolers, freezers, vending machines, cold rooms, kitchen refrigerators, supermarket freezers, and more.
Strong R&D Capabilities and World-Class Innovation Center
With over 280 professional engineers averaging 10 years of experience, Aucma maintains strong technological leadership. The company has invested USD 6 million in a CNAS-approved global innovation test center covering 4,500 m², with test results recognized by VDE, UL, CSA, and CCC. Aucma leads in cryogenic quick-freezing, ultra-low temperature technology, precise temperature control, and new energy applications.
Extensive Professional Certifications & International Compliance
Aucma holds major global certifications, including WHO-PQS, ISO13485, ISO9001, ISO14001, ISO45001, CE, and UL. The company is also licensed and approved by national regulatory authorities for medical device manufacturing and registration. These certifications ensure world-class quality, safety, and reliability across all scientific, medical, and industrial cold-chain equipment.




Contact Us
Partner with Aucma today and experience world-class refrigeration technology designed to power your success.
FAQs
Related Blogs
Solar Direct Drive Refrigerators: Powering Off‑Grid Vaccine Cold Chains
Solar Direct Drive Refrigerators: Powering OffGrid Vaccine Cold ChainsIn a world where vaccine storage and distribution are critical to public health, particularly in remote regions with limited or no access to reliable power, the need for innovative, sustainable, and cost-effective cold chain solu
Read MoreSolar Direct Drive Vs Traditional Solar Refrigerators: What’s The Difference?
Solar Direct Drive vs Traditional Solar Refrigerators: What’s the Difference?As the world increasingly turns to renewable energy for its environmental benefits, solar-powered refrigeration systems are becoming a key solution in off-grid cold chain applications, especially in regions with unreliable
Read MoreWhy Solar Direct Drive Refrigerators Are The Future of Off‑Grid Cooling
Why Solar Direct Drive Refrigerators Are the Future of Off-Grid CoolingOff-grid cooling solutions have become essential in many sectors, particularly in healthcare, agriculture, and disaster relief efforts. Traditional refrigeration systems are often reliant on an unreliable grid or costly fuel-powe
Read MoreSolar Direct Drive Refrigeration Solutions for Global Health
Solar Direct Drive Refrigerator: A Sustainable Refrigeration Solution for Global HealthIn the rapidly evolving field of global healthcare, ensuring the safety and stability of critical medical products, such as vaccines, blood, and pharmaceuticals, is of utmost importance. The Solar Direct Drive Ref
Read MoreGet Touch With Us

Contact Info
For inquiries about our comprehensive laboratory incubator solutions, technical specifications, customization options, or application support, please contact our dedicated laboratory equipment specialists.
+86 532 86762805
info@aucma.com.cn